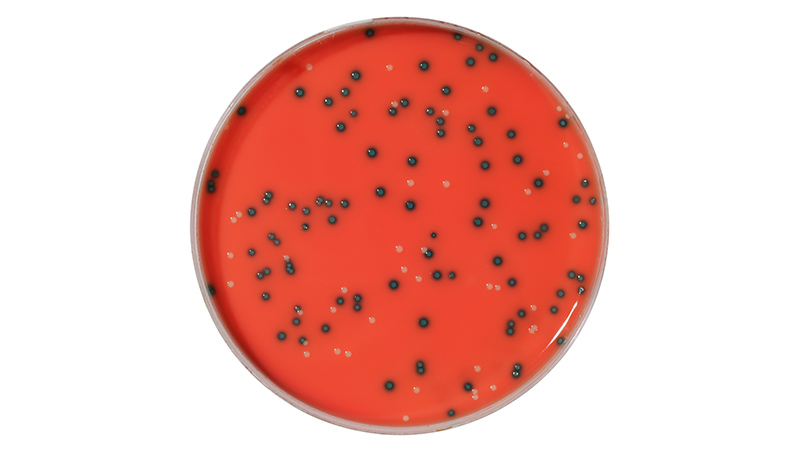
产品四.jpg
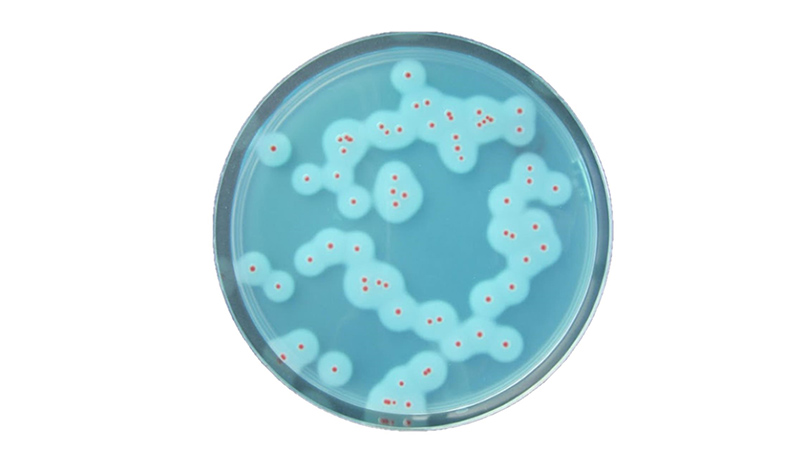
产品六.jpg

作为食品安全技术领域规模最大、人气最旺和最受欢迎的行业盛会之一,CBIFS第十八届食品安全技术论坛暨太平洋食安展将于2026年4月9日-10日在苏州举办。
伯乐公司确认参展本次论坛,欢迎各位领导专家和客户朋友参观交流、合作洽谈!


伯乐生命医学产品(上海)有限公司
Bio-Rad Laboratories, Inc. (简称Bio-Rad) 是一家创建于1952年,总部设在美国加州的跨国企业。60多年来,Bio-Rad不懈致力于在生命科学及临床诊断领域提供成熟且高质量的产品,并成为相关领域的知名品牌。
食品科学部是Bio-Rad专门提供食品安全检测方案的业务部。1999年Bio-Rad收购了Pasteur Sanofi Diagnostics公司,2001年,因成功帮助控制了当年欧洲疯牛病疫情,Bio-Rad公司在微生物及食品安全监测领域的实力和市场地位也大大增强。 Bio-Rad始终结合生命科学部坚实的科学基础,以及法国巴斯德研究所传承的微生物专业强项,发展了一系列优质的食品安全监测技术和全面独特的解决方案。近三年Bio-Rad引领的数字PCR技术也恰好地开创了食物品质真实性检测的新纪元。
电话:8621 61698500
地址:上海市杨浦区荆州路168号安联大厦601室 邮编: 200082
网址:www.bio-rad.com

- 扫码关注公众号 -

EZ-Check 沙门氏菌实时PCR检测试剂盒
EZ-Check 沙门氏菌实时PCR检测试剂盒是新一代快速、精准的沙门氏菌检测方案,适用于各类食品、动物饲料及环境样品。该试剂盒高品质、操作简便,专为服务型实验室、企业实验室及政府实验室设计,可高效检测沙门氏菌 DNA, 并已获得AOAC和AFNOR国际认证证书.

EZ-Check 李斯特菌实时PCR检测试剂盒
EZ-Check 李斯特菌实时PCR检测试剂盒是新一代快速、精准的检测方案,适用于各类食品及环境样品。该试剂盒已获得AOAC国际认证证书, 高品质设计使其成为企业实验室、服务型实验室及政府实验室保障食品安全的理想选择.

RAPID'Salmonella 显色培养基
RAPID'Salmonella 可用于食品中典型及非典型沙门氏菌的检测和计数的显色培养基。该方法是基于两种特异性酶C8酯酶和β-D葡糖苷酶而产生紫红色菌落用于区分沙门氏菌和其他杂菌。 能在40小时内获得结果,且获得AOAC, AFNOR和NordVal等国际认证证书。
RAPID’L.mono 显色培养基
RAPID’L.mono 可用于食品和环境样品中单增李斯特菌的检测和计数的显色培养基。该方法针对单增李斯特菌的特异性产生磷脂酶C和木糖的特性而设计,能在44小时后产生蓝色的菌落,并获得AOAC, AFNOR和NordVal等国际认证证书。

RAPID'Cronobacter 显色培养基
RAPID'Cronobacter 用于乳制品中克罗诺杆菌的检测和计数的显色培养基。该方法基于克罗诺杆菌特异性酶葡萄糖苷酶,能在40小时后产生蓝绿色的菌落,并获得AFNOR国际认证证书。
RAPID’B.cereus显色培养基
RAPID’B.cereus 是全球第一款用于食品样本中所有致病性蜡样芽胞杆菌群包括细胞毒性芽胞杆菌的检测及计数的显色培养基。能在24小时内给出结果, 无需确认。在蓝色背景下清楚呈现红色菌落及其沉淀环,并获得AFNOR国际认证证书。




